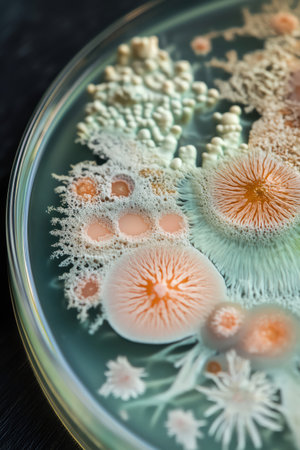
A detailed view of a Petri dish showcasing diverse stages of microbial growth and patternsの素材

素材 - A detailed view of a Petri dish showcasing diverse stages of microbial growth and patterns
作品情報
A detailed view of a Petri dish showcasing diverse stages of microbial growth and patterns
- ID:282116509
- 作品種別:
- 作者名:teerapong salaisook
キーワード
- agarose
- bacteria
- behavior
- cellular
- colony
- color
- condition
- detail
- dish
- diverse
- dynamic
- ecosystem
- environment
- evolution
- experiment
- fauna
- flora
- formation
- fungi
- growth
- image
- incubation
- interaction
- isolation
- microbial
- microscopy
- morphology
- nutrient
- observation
- organism
- pattern
- petri
- replication
- showcase
- species
- stage
- statistics
- surround
- suspension
- view
類似作品
black plate wit...
Bacterial cultu...
Laboratory glas...
Close up the me...
Laboratory tech...
Backgrounds of ...
chemist wearing...
Petri dish with...
Petri dish with...
Backgrounds of ...
Scientist Works...
Backgrounds of ...
A hand in dispo...
Male doctor wor...
photo of fungi ...
Viruses and bac...
A researcher in...
Petri dish with...
Homemade facial...
covid-19 medici...
bacterial colon...
Close-up of bac...
Antimicrobial s...
cosmetic cream ...
cooking Tartar ...
Mushroom cultiv...
top view resear...
A petri dish wi...
Research, man o...
Molds colonies ...
Closeup of bota...
Hands, plant sc...
Agar plate with...
Penicillium, as...
Doctor holding ...
scientist worki...
tea mold in a c...
The male doctor...
epidemic and th...
chemist at blue...
Backgrounds of ...
GREEK SPOON SWE...
Cultured yeasts...
Hand in blue gl...
Backgrounds of ...
Research, exper...
Germination and...
E. coli growing...
Biochemistry. S...